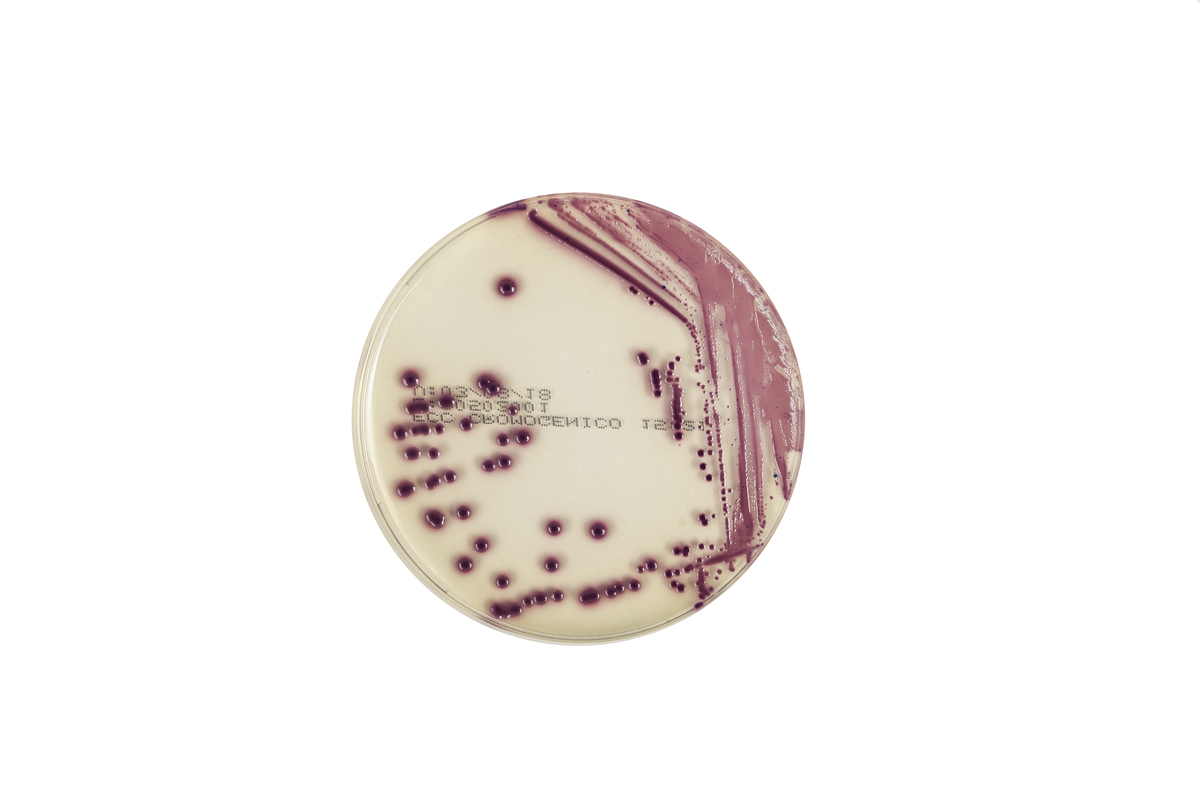
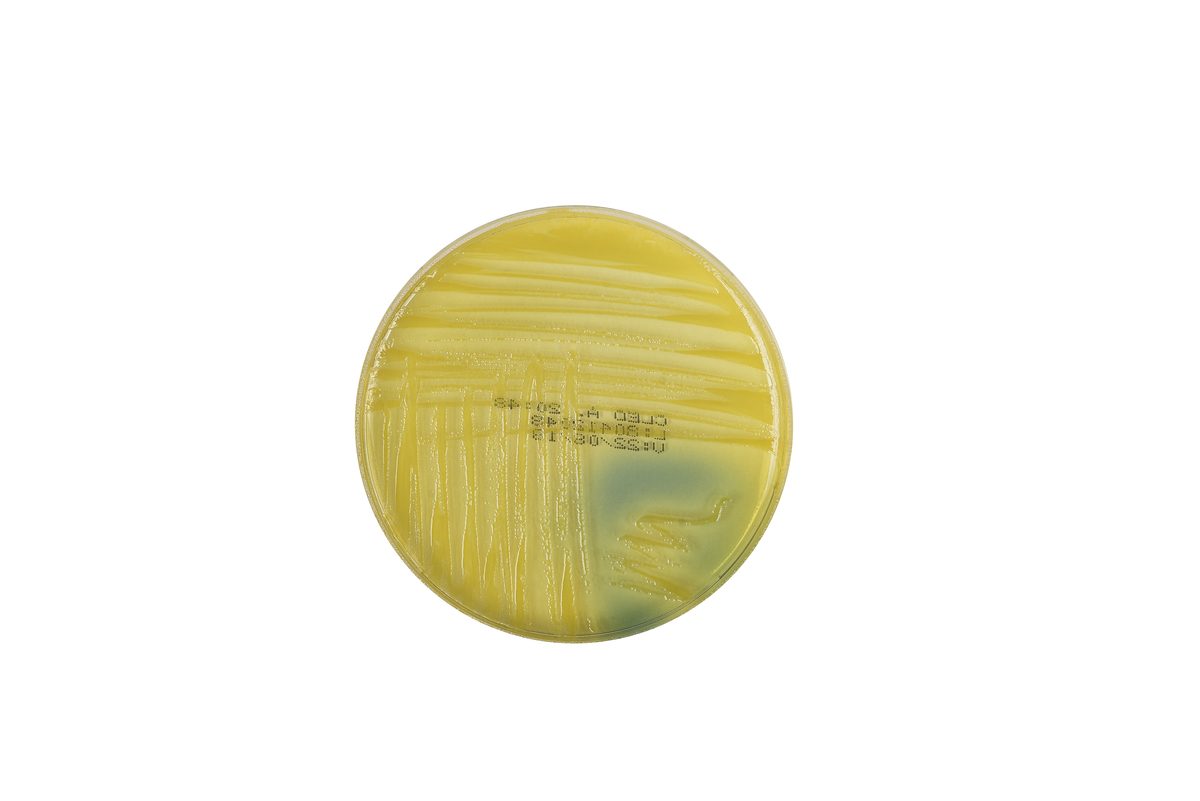
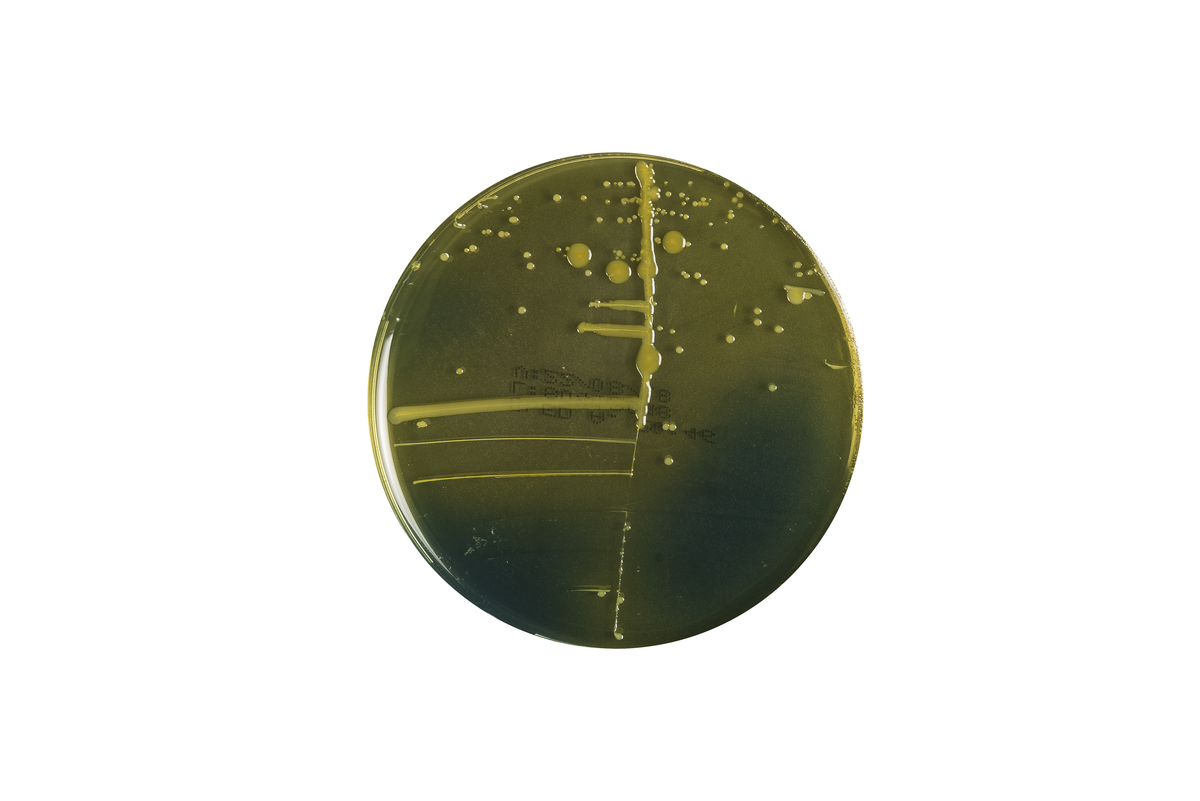

Produtos
Laborclin
Fotografia de produtos, itens para laboratório, colônia de bactérias.
Realizada com iluminação artificial, em fundo infinito, para o novo catálogo da empresa.









Fotografia de produtos, itens para laboratório, colônia de bactérias.
Realizada com iluminação artificial, em fundo infinito, para o novo catálogo da empresa.